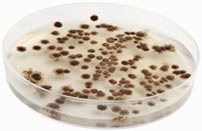
mold_01

No matter who you are, or where you live, everyone needs to reduce the amount of mold and mildew in the air they are breathing in. If you smell a musty odor in your home or workplace, there is a good chance that it is probably mold or mildew.Of course, if you actually see mold in your home or office, then you know you have a problem. The bad news is, most of the toxic mold floating around in our air is actually invisible to the naked eye, but still may be seriously affecting your health.
Ancient oriental medicine tells us that clean, fresh air, is one of the most important components of not only physical, but also mental health. Simply put, without clean air, the body cannot function properly. When the body is not functioning properly, the mind cannot function with ease and clarity.The word disease literally means, “dis-ease,” or being in a place where the body is not at ease. Without oxygen, we cannot live. With unclean air, we may be able to sustain ourselves, but we will not be at ease, or free of disease.This is one of the reasons why the presence of mold and mildew in our indoor air has been clinically associated with more than just allergic reactions. Some studies show a link between airborne mold spores and depression, and even death! [1]Many similar studies have shown that the average human being breathes in an incredibly high amount of toxins from environmental air. In fact, with each breath, we take in more toxic substances and less of the vital oxygen that we need, than ever before.
Mold & Mildew: Where Does it Lurk?
Most molds are microscopic fungi that grow on a host surface, like a loaf of bread or a musty, kitchen cabinet. The green mold you see on an old loaf of bread is not one mold, but is actually clusters of hundreds of connected networks of mold.

Each mold spore clusters together using tiny, tubular arms to create a singular organism, commonly referred to as a cluster. This clustered type of mold is visible.
But, high amounts of “un-clustered” microscopic individual mold spores are often moving through our airspace. These spores are completely invisible to the human eye. For this reason, mold and mildew can be hard to spot, and therefore even harder to get rid of.
Although a small amount of mold and mildew won’t hurt most of us, it begins to become a big problem when the mold spores get out of hand. When quantity does get out of hand, or when individuals who are highly sensitive to toxic mold, breathe it in, it can present a serious health hazard. Mold and mildew are known to cause respiratory problems, common allergic reaction symptoms, nervous-system disorders and depression.
In particular, there are certain types of molds that produce what are called mycotoxins [2]. These molds are particularly dangerous and create a toxic breathing environment for you, your children and your pets. Studies have shown that breathing in large amounts of these mycotoxins can impair the entire human system, and can even lead to death.
Eye Opening Statistics About Mold:
A groundbreaking report from 2007 stated that scientists found a direct correlation between a high presence of mold in households and depression.
- Even more shockingly, studies have shown that the air inside our homes can be worse than the air outside. The average American spends around 90% of our time in enclosed buildings, and over 60% of our time in our houses. [3]
- Scientists have identified over 1,000 types of mold and mildew inside houses in the United States. [4]
- More than 100,000 types of mold exist!
- “Stachybotrys” is a highly-toxic type of mold that has been related to human death.
Toxic Mold: How It Survives
Mold lives off of any organic matter and loves a warm, humid environment. This includes your leather jacket, a peach, old newspapers, bathroom walls, windowsills, ceilings, and wall-paper. Most often, mildew, which is a form of mold or fungus, infests our living or workspaces when there is a high level of moisture, like a musty basement or a shower wall. It comes in through our walls, windows, doors, carpets, or under the refrigerator.
Mold spores can also be carried in on our clothing, shoes, pets and our bodies. Doctors warn against breathing in mold over long periods of time. Often times, our homes and offices are infested with toxic mold and mildew. And, because it can hide in cracks in our walls, as well as other invisible places, most of us are unaware that we are being exposed to the extremely harmful effects.
Today, mold growth in homes and places of work is more of a health issue than we may think. So it’s important that you recognize the symptoms of mold in your home, and take steps to protect yourself and your family.
For further information, please read this blog post about how to get rid of mold.
References (4)
- Brown University. Household Mold Linked To Depression. ScienceDaily. 2007 August 30
- Bennett JW, Klich M. Mycotoxins. Clin Microbiol Rev. 2003 Jul;16(3):497-516. Review.
- Collin Dunn. Indoor air quality: cause of, testing, and monitoring indoor air pollution. Tree Hugger. 2007 October 11.
- “Safety and Health Information Bulletins. U.S. Department of Labor | A Brief Guide to Mold in the Workplace. 2009. 29 Feb. 2016.
Related Posts
Share this:
- Share on Tumblr (Opens in new window) Tumblr
- Print (Opens in new window) Print
- Email a link to a friend (Opens in new window) Email
- Share on StumbleUpon (Opens in new window) StumbleUpon
- Share on Reddit (Opens in new window) Reddit
- Share on WhatsApp (Opens in new window) WhatsApp
- Share on Telegram (Opens in new window) Telegram
- Share on LinkedIn (Opens in new window) LinkedIn
- Share on Facebook (Opens in new window) Facebook
- Share on X (Opens in new window) X
- Share on Pinterest (Opens in new window) Pinterest


16 thoughts on “The Dangers of Mold & Mildew in your Home or Office”